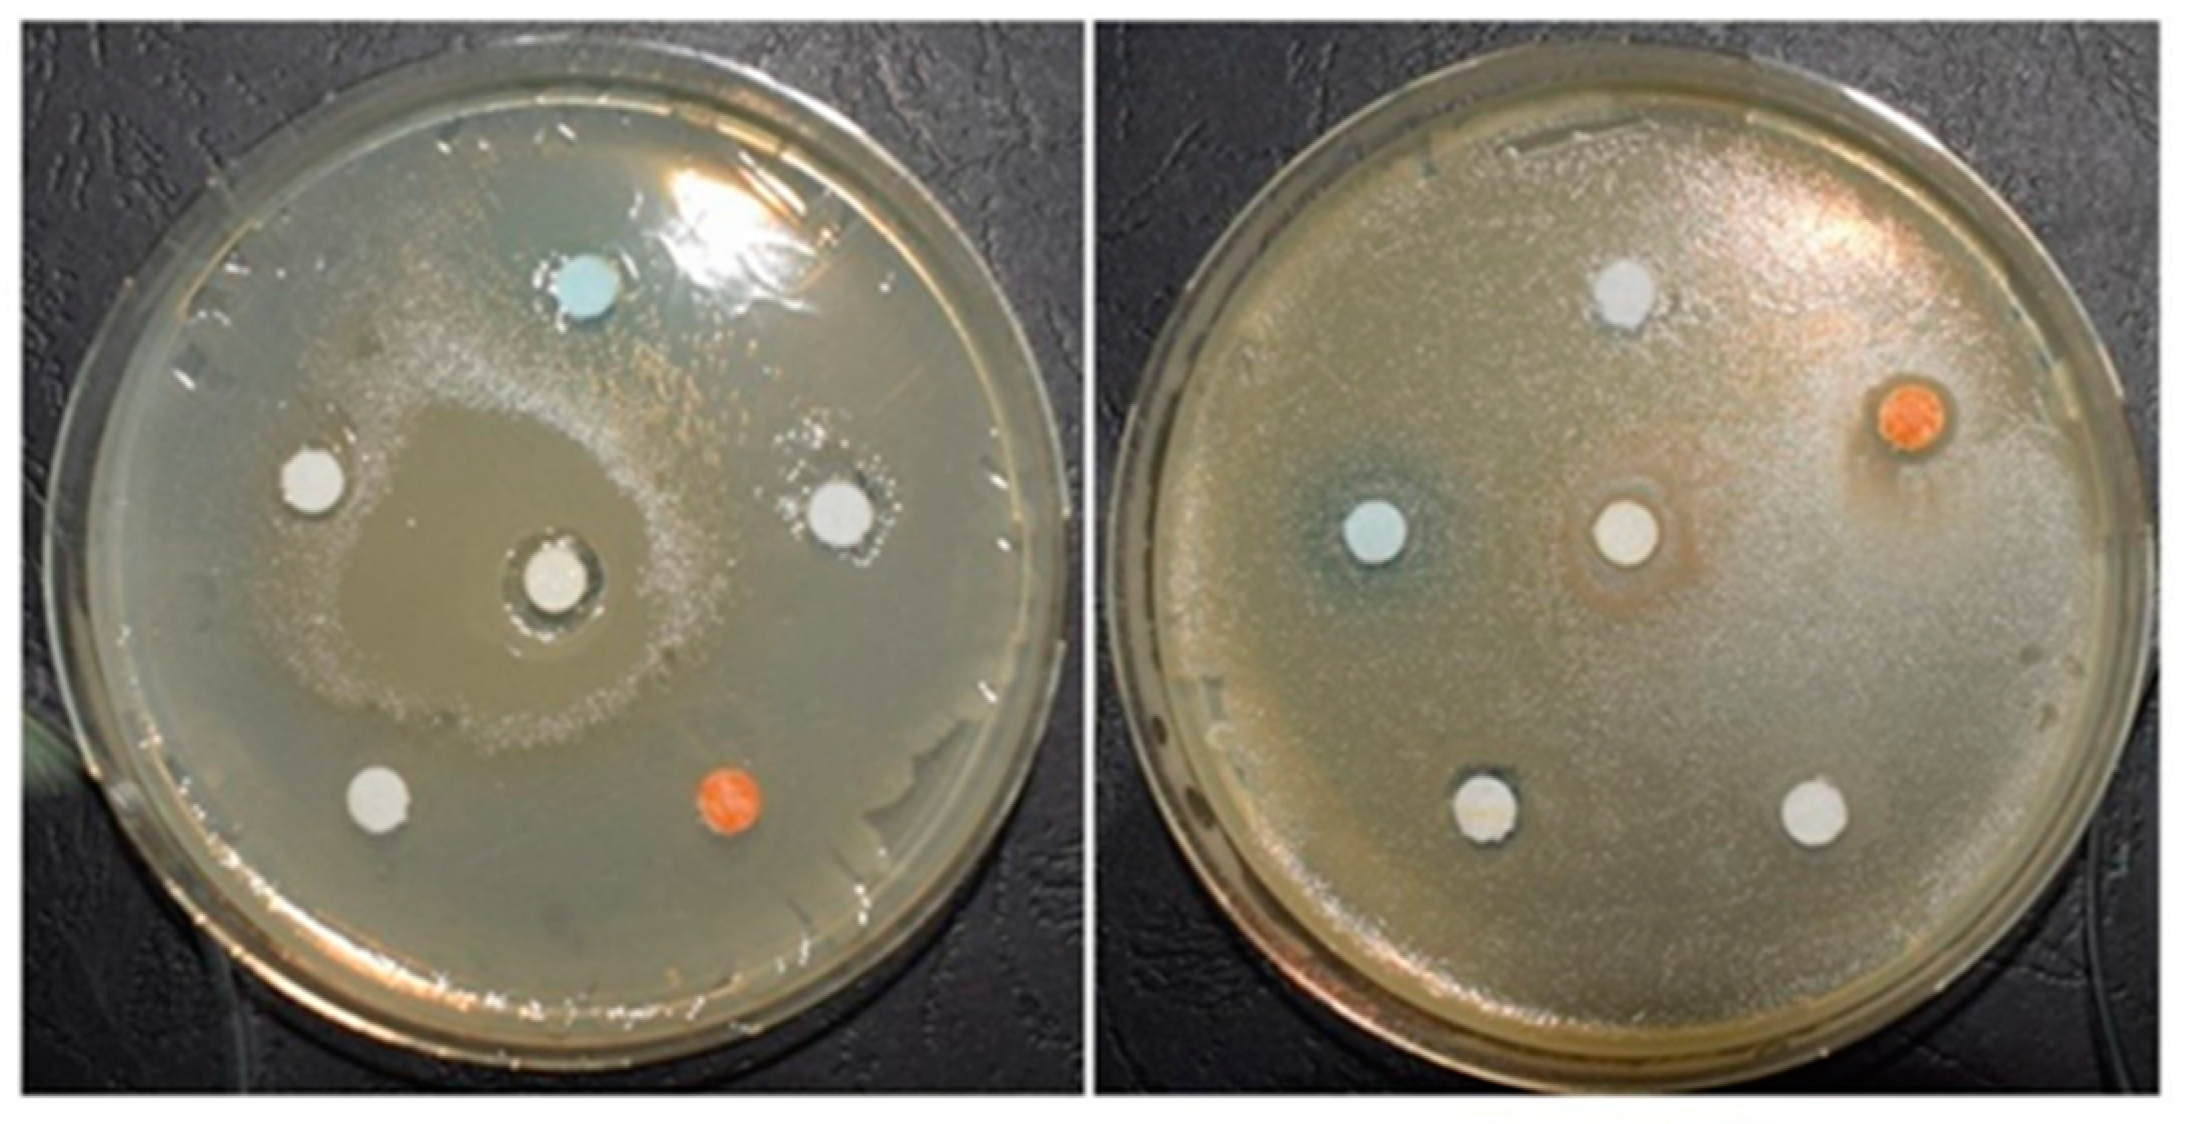
Materials 13 03012 g005

Assessment and Characterization of Some New Photosensitizers for Antimicrobial Photodynamic Therapy (aPDT)
Abstract
:1. Introduction
2. Materials and Methods
2.1. Materials
2.1.1. Experimental Photosensitizers (PS)
2.1.2. Photodynamic Therapy Protocol (PDT)
2.2. The Gas Chromatography-Mass Spectrometry (GC-MS)
2.3. Characterization of Experimental PS by UV-VIS Spectroscopy
2.4. Determination of IR Spectra for Experimental PS (Essential Oil Gels)
2.5. Cytotoxicity Determination of Experimental Gels
2.5.1. Cell Culture
2.5.2. Extract Preparation
2.5.3. Cytotoxicity Assay
2.5.4. Statistical Analysis
2.6. Determination of the Antimicrobial Effect of the Experimental Gels
2.7. The Efficiency of Photodynamic Antimicrobial Therapy on Extracted Teeth
Microstructural Analysis by SEM
3. Results
3.1. GC-MS Analysis of Gels Containing Essential Oils
3.2. Determination of UV-Vis Spectra for Experimental PS
3.3. Determination of IR Spectra for Experimental PS
3.4. Cytotoxicity Assessment of Natural Photosensitizers
3.5. The Efficiency of Antimicrobial Activity of Experimental PS
3.6. The Efficacy of Photodynamic Antimicrobial Therapy on Extracted Teeth, without Enamel Lesions. Microstructural Analysis by SEM, after Bacterial Colonization and after Treatment with PS
4. Discussion
5. Conclusions
Author Contributions
Funding
Conflicts of Interest
References
- Beikler, T.; Flemmig, T.F. Oral biofilm-associated diseases: Trends and implications for quality of life, systemic health and expenditures. Periodontol. 2000 2011, 55, 87–103. [Google Scholar] [CrossRef]
- Fontana, C.R.; Abernethy, A.D.; Som, S.; Ruggiero, K.; Doucette, S.; Marcantonio, R.C.; Boussios, C.I.; Kent, R.; Goodson, J.M.; Tanner, A.C.; et al. The antibacterial effect of photodynamic therapy in dental plaque-derived biofilms. J. Periodontal. Res. 2009, 44, 751–759. [Google Scholar] [CrossRef]
- Costerton, J.W.; Stewart, P.S.; Greenberg, E.P. Bacterial biofilms: A common cause of persistent infections. Science 1999, 284, 1318–1322. [Google Scholar] [CrossRef] [Green Version]
- Kroes, I.; Lepp, P.; Relman, D.A. Bacterial diversity within the human subgingival crevice. Proc. Natl. Acad. Sci. USA 1999, 96, 14547–14552. [Google Scholar] [CrossRef] [PubMed] [Green Version]
- Kornman, K.S.; Page, R.C.; Tonetti, M.S. The host response to the microbial challenge in periodontitis: Assembling the players. Periodontol. 2000 1997, 14, 33–53. [Google Scholar] [CrossRef] [PubMed]
- Azaripour, A.; Dittrich, S.; Van Noorden, C.J.F.; Willershausen, B. Efficacy of photodynamic therapy as adjunct treatment of chronic periodontitis: A systematic review and meta-analysis. Lasers Med. Sci. 2018, 33, 407–423. [Google Scholar] [CrossRef] [PubMed]
- Ardila, C.M.; Lopez, M.A.; Guzman, I.C. High resistance against clindamycin, metronidazole and amoxicillin in Porphyromonas gingivalis and Aggregatibacteractinomycetemcomitans isolates of periodontal disease. Med. Oral Patol. Oral Cir. Bucal 2010, 15, E947–E951. [Google Scholar] [CrossRef] [PubMed] [Green Version]
- Cadore, U.B.; Reis, M.; Martins, S.; Invernici, M.M.; Novaes, A.B., Jr.; Taba, M., Jr.; Palioto, D.B.; Messora, M.R.; Souza, S.L.S. Multiple sessions of antimicrobial photodynamic therapy associated with surgical periodontal treatment in patients with chronic periodontitis. J. Periodontol. 2019, 90, 339–349. [Google Scholar] [CrossRef] [PubMed]
- Diogo, P.; Fernandes, C.; Caramelo, F.; Mota, M.; Miranda, I.M.; Faustino, M.A.F.; Neves, M.G.P.M.S.; Uliana, M.P.; de Oliveira, K.T.; Santos, J.M.; et al. Antimicrobial Photodynamic Therapy against Endodontic Enterococcus faecalis and Candida albicans Mono and Mixed Biofilms in the Presence of Photosensitizers: A Comparative Study with Classical Endodontic Irrigants. Front. Microbiol. 2017, 8, 498. [Google Scholar] [CrossRef] [PubMed] [Green Version]
- Tavares, A.; Carvalho, C.M.B.; Faustino, M.A.; Neves, M.G.P.M.S.; Tomé, J.P.C.; Tomé, A.C.; Cavaleiro, J.A.S.; Cunha, Â.; Gomes, N.C.M.; Alves, E.; et al. Antimicrobial photodynamic therapy: Study of bacterial recovery viability and potential development of resistance after treatment. Mar. Drugs 2010, 8, 91–105. [Google Scholar] [CrossRef] [Green Version]
- Costa, L.; Tomé, J.P.C.; Neves, M.G. Evaluation of resistance development and viability recovery by a non-enveloped virus after repeated cycles of aPDT. Antivir. Res. 2011, 91, 278–282. [Google Scholar] [CrossRef] [PubMed]
- Kwiatkowski, S.; Knap, B.; Przystupski, D.; Saczko, J.; Kędzierska, E.; Knap-Czop, K.; Kotlińska, J.; Michel, O.; Kotowski, K.; Kulbacka, J. Photodynamic therapy - mechanisms, photosensitizers and combinations. Biomed. Pharmacother. 2018, 106, 1098–1107. [Google Scholar] [CrossRef] [PubMed]
- Plotino, G.; Grande, N.M.; Mercade, M. Photodynamic therapy in endodontics. Int. Endod. J. 2019, 52, 760–774. [Google Scholar] [CrossRef] [Green Version]
- Meisel, P.; Kocher, T. Photodynamic therapy for periodontal diseases: State of the art. J. Photochem. Photobiol. B 2005, 79, 159–170. [Google Scholar] [CrossRef] [PubMed]
- Sigusch, B.W.; Pfitzner, A.; Albrecht, V.; Glockmann, E. Efficacy of photodynamic therapy on inflammatory signs and two selected periodontopathogenic species in a beagle dog model. J. Periodontol. 2005, 76, 1100–1105. [Google Scholar] [CrossRef] [PubMed]
- Pinheiro, S.L.; Schenka, A.A.; Neto, A.A.; de Souza, C.P.; Rodriguez, H.M.; Ribeiro, M.C. Photodynamic therapy in endodontic treatment of deciduous teeth. Lasers Med. Sci. 2009, 24, 521–526. [Google Scholar] [CrossRef] [PubMed]
- Lyon, J.P.; Moreira, L.M.; de Moraes, P.C.; dos Santos, F.V.; de Resende, M.A. Photodynamic therapy for pathogenic fungi. Mycoses 2011, 54, e265–e271. [Google Scholar] [CrossRef] [PubMed]
- Kubler, A. Photodynamic therapy. Med. Laser Appl. 2005, 20, 37–45. [Google Scholar] [CrossRef]
- Nagata, J.Y.; Hioka, N.; Kimura, E.; Batistela, V.R.; Terada, R.S.; Graciano, A.X.; Baesso, M.L.; Hayacibara, M.F. Antibacterial photodynamic therapy for dental caries: Evaluation of the photosensitizers used and light source properties. Photodiagnosis Photodyn. Ther. 2012, 9, 122–131. [Google Scholar] [CrossRef]
- Santezi, C.; Reina, D.B.; Dovigo, L.N. Curcumin-mediated Photodynamic Therapy for the treatment of oralinfections—A review. Photodiagnosis Photodyn. Ther. 2018, 21, 409–415. [Google Scholar] [CrossRef] [Green Version]
- Bruzell, E.M.; Morisbaka, E.; Tønnesen, H.H. Studies on curcumin and curcuminoids. XXIX. Photoinduced cytotoxicity of curcumin in selected aqueous preparations. Photochem. Photobiol. Sci. 2005, 4, 517–522. [Google Scholar] [CrossRef]
- Shitomi, K.; Miyaji, H.; Miyata, S.; Sugaya, T.; Ushijima, N.; Akasaka, T. Photodynamic inactivation of oral bacteria with silver nanoclusters/rose bengal nanocomposite. Photodiagnosis Photodyn. Ther. 2020, 30, 101647. [Google Scholar] [CrossRef] [PubMed]
- Nikinmaa, S.; Alapulli, H.; Auvinen, P.; Vaara, M.; Rantala, J.; Kankuri, E. Dual-light photodynamic therapy administered daily provides a sustained antibacterial effect on biofilm and prevents Streptococcus mutans adaptation. PLoS ONE 2020, 15, e0232775. [Google Scholar] [CrossRef] [PubMed]
- Azizi, A.; Shohrati, P.; Goudarzi, M.; Lawaf, S.; Rahimi, A. Comparison of the effect of photodynamic therapy with curcumin and methylene blue on Streptococcus mutans bacterial colonies. Photodiagnosis Photodyn. Ther. 2019, 27, 203–209. [Google Scholar] [CrossRef] [PubMed]
- Marqués-Calvo, M.S.; Codony, F.; Agustí, G.; Lahera, C. Visible light enhances the antimicrobial effect of some essential oils. Photodiagnosis Photodyn. Ther. 2017, 17, 180–184. [Google Scholar] [CrossRef] [Green Version]
- Kang, S.M.; Jung, H.I.; Kim, B.I. Susceptibility of oral bacteria to antibacterial photodynamic therapy. J. Oral Microbial. 2019, 11, 1644111. [Google Scholar] [CrossRef] [Green Version]
- Wood, S.; Metcalf, D.; Devine, D.; Robinson, C. Erythrosine is a potential photosensitizer for the photodynamic therapy of oral plaque biofilms. J. Antimicrob. Chemother. 2006, 57, 680–684. [Google Scholar] [CrossRef]
- Wilson, M. Photolysis of oral bacteria and its potential use in the treatment of caries and periodontal disease: A review. J. Appl. Bacteriol. 1993, 75, 299–306. [Google Scholar] [CrossRef]
- Cavalcanti, B.N.; Rode, S.M.; Marques, M.M. Cytotoxicity of substances leached or dissolved from pulp capping materials. Int. Endod. J. 2005, 38, 505–509. [Google Scholar] [CrossRef]
- ISO 10993-12: Biological Evaluation of Medical Devices—Part 12: Sample Preparation and Reference Materials; International Standards Organization for Standardization: Geneva, Switzerland, 2012.
- Carpa, R.; Dragan-Bularda, M.; Muntean, V. General Microbiology-Practical Works, 1st ed.; Cluj University Press: Cluj-Napoca, Romania, 2014. [Google Scholar]
- Park, K.; Lee, J.H. Photosensitizer effect of curcumin on UVB-irradiated HaCaT cells through activation of caspase pathways. Oncol. Rep. 2007, 17, 537–540. [Google Scholar] [CrossRef]
- Dovigo, L.N.; Pavarina, A.C.; Ribeiro, A.P.D.; Brunetti, I.L.; Costa, C.A.; Jacomassi, D.P. Investigation of the photodynamic effects of curcumin against Candida albicans. Photochem. Photobiol. 2011, 87, 895–903. [Google Scholar] [CrossRef] [PubMed]
- Dorman, H.; Deans, S.G. Antimicrobial agents from plants: Antibacterial activity of plant volatile oils. J. Appl. Microbiol. 2000, 88, 308–316. [Google Scholar] [CrossRef] [PubMed]
- Max, J.J.; Chapados, C. Isotope effects in liquid water by infrared spectroscopy. III. H2O and D2O spectra from 6000 to 0 cm−1. J. Chem. Phys. 2009, 131, 184505. [Google Scholar] [CrossRef] [PubMed]
- Bergo, P.; Carvalho, R.A.; Vadala, A.C.S.; Guevara, V.C.I.; Sobral, P.J.A. Physical properties of gelatin films plasticized with glycerol, studied by spectroscopic methods. Mater. Sci. Forum 2010, 636, 753–758. [Google Scholar] [CrossRef]
- Jeevithan, E.; Bao, B.; Bu, Y.; Zhou, Y.; Zhao, Q.; Wu, W. Type II collagen and gelatin from silvertip shark (Carcharhinusalbimarginatus) cartilage: Isolation, purification, physicochemical and antioxidant properties. Mar. Drugs 2014, 12, 3852–3873. [Google Scholar] [CrossRef] [Green Version]
- Ning, N.; Wang, Z.; Yao, Y.; Zhang, L.; Tian, M. Enhanced electromechanical performance of bio-based gelatin/glycerin dielectric elastomer by cellulose nanocrystals. Carbohydr. Polym. 2015, 130, 262–267. [Google Scholar] [CrossRef]
- Morsy, R.; Hosny, M.; Reicha, F.; Elnimr, T. Developing and physicochemical evaluation of cross-linked electrospun gelatin–glycerol nanofibrous membranes for medical applications. J. Mol. Struct. 2017, 1135, 222–227. [Google Scholar] [CrossRef]
- Bakkali, F.; Averbeck, S.; Averbeck, D.; Idaomar, M. Biological effects of essential oils—A review. Food Chem. Toxicol. 2008, 46, 446–475. [Google Scholar] [CrossRef]
- Coccimiglio, J.; Alipour, M.; Jiang, Z.H.; Gottardo, C.; Suntres, Z. Antioxidant, antibacterial, and cytotoxic activities of the ethanolicOriganum vulgare extract and its major constituents. Oxid. Med. Cell. Longev. 2016, 2016, 1404505. [Google Scholar] [CrossRef] [Green Version]
- Ruberto, G.; Baratta, M.T. Antioxidant activity of selected essential oil components in two lipid model systems. Food Chem. 2000, 69, 167–174. [Google Scholar] [CrossRef]
- Siegfried, S.A.; Schroeder, J.R. Toxicity of thieves oils to mcf-7 and mda-mb-231 breast cancer cells. Am. J. Essent. Oils Nat. Prod. 2018, 6, 1–8. [Google Scholar]
- Mandrol, P.S.; Bhat, K.; Prabhakar, A.R. An in vitro evaluation of cytotoxicity of curcumin against human dental pulp fibroblasts. J. Indian Soc. Pedod. Prev. Dent. 2016, 34, 269–272. [Google Scholar] [CrossRef] [PubMed]
- Poljsak, B.; Milisav, I. The Neglected Significance of “Antioxidative Stress”. Oxid. Med. Cell. Longev. 2012, 2012, 480895. [Google Scholar] [CrossRef] [PubMed] [Green Version]
- Hu, X.; Huang, Y.Y.; Wang, Y.; Wang, X.; Hamblin, M.R. Antimicrobial Photodynamic Therapy to Control Clinically Relevant Biofilm Infections. Front. Microbiol. 2018, 27, 1299. [Google Scholar] [CrossRef] [PubMed] [Green Version]
- Shrestha, A.; Shi, Z.; Neoh, K.G.; Kishen, A. Nanoparticulates for antibiofilm treatment and effect of aging on its antibacterial activity. J. Endod. 2010, 36, 1030–1035. [Google Scholar] [CrossRef]
- Luke-Marshall, N.R.; Mang, T.S.; Hansen, L.A.; Campagnari, A.A. Moraxella catarrhalis is susceptible to antimicrobial photodynamic therapy with Photofrin. Lasers Surg. Med. 2014, 46, 712–717. [Google Scholar] [CrossRef]
- Shrestha, A.; Kishen, A. Antibiofilm efficacy of photosensitizer-functionalized bioactive nanoparticles on multispecies biofilm. J. Endod. 2014, 40, 1604–1610. [Google Scholar] [CrossRef]
- Burt, S. Essential oils: Their antibacterial properties and potential applications in foods—A review. Int. J. Food Microbiol. 2004, 94, 223–253. [Google Scholar] [CrossRef]
- Mohamed, A.A.; Ali, S.I.; Kabiel, H.F.; Hegazy, A.K.; Kord, M.A.; EL-Baz, F.K. Assessment of Antioxidant and Antimicrobial Activities of Essential Oil and Extracts of Boswelliacarteri Resin. Int. J. Pharm. Phytochem. Res. 2015, 7, 502–509. [Google Scholar]
- Baser, K.H.C. The Turkish Origanum species. In Oregano: The Genera Origanum and Lippia, 1st ed.; Kintzios, S.E., Ed.; Taylor and Francis: New York, NY, USA, 2002; pp. 109–126. [Google Scholar]
- Lambert, R.J.; Skandamis, P.N.; Coote, P.J.; Nychas, G.J.E. A study of the minimum inhibitory concentration and mode of action of oregano essential oil, thymol and carvacrol. J. Appl. Microbiol. 2001, 91, 453–462. [Google Scholar] [CrossRef] [Green Version]
- Preuss, H.G.; Echard, B.; Enig, M.; Brook, I.; Elliott, T.B. Minimum inhibitory concentrations of herbal essential oils and monolaurin for gram-positive and gram-negative bacteria. Cell. Mol. Biol. 2005, 272, 29–34. [Google Scholar] [CrossRef] [PubMed]
- Zhou, R.; Wu, J.; Zhang, L.; Liu, L.; Casper, D.P.; Jiao, T.; Liu, T.; Wang, J.; Lang, X.; Song, S.; et al. Effects of oregano essential oil on the ruminal pH and microbial population of sheep. PLoS ONE 2019, 14, e0217054. [Google Scholar] [CrossRef] [PubMed]
- Afrasiabi, S.; Pourhajibagher, M.; Chiniforush, N.; Aminian, M.; Bahador, A. Anti-biofilm and anti-metabolic effects of antimicrobial photodynamic therapy using chlorophyllin-phycocyanin mixture against Streptococcus mutans in experimental biofilm caries model on enamel slabs. Photodiagnosis Photodyn. Ther. 2020, 29, 101620. [Google Scholar] [CrossRef] [PubMed]
- Jones, S.B.; West, N.X.; Nesmiyanov, P.P.; Krylov, S.E.; Klechkovskaya, V.V.; Arkharova, N.A. The antibacterial efficacy of a foam mouthwash and its ability to remove biofilms. BDJ Open 2018, 4, 1–5. [Google Scholar] [CrossRef]

| No. | Compounds | RT | RI | A% | O% | T% | H% | Family |
|---|---|---|---|---|---|---|---|---|
| 1 | α-Thujene | 8.702 | 814 | - | - | 2.25 | - | monoterpene |
| 2 | α-Pinene | 8.865 | 820 | 11.93 | 1.00 | 42.88 | 2.05 | monoterpene |
| 3 | Camphene | 9.118 | 831 | - | 0.17 | 0.78 | 0.13 | monoterpene |
| 4 | Sabinene | 9.634 | 848 | - | - | 2.75 | 0.46 | monoterpene |
| 5 | 1-Octen-3-ol | 9.665 | 849 | - | 0.63 | - | alcohol | |
| 6 | β-Pinene | 9.739 | 852 | - | 0.62 | 1.39 | 3.70 | monoterpene |
| 7 | 3-Octanone | 9.812 | 854 | - | 0.30 | - | ketone | |
| 8 | β-Mircene | 9.908 | 858 | - | 0.74 | 3.56 | 0.46 | monoterpene |
| 9 | 3-Octanol | 9.977 | 860 | - | 0.16 | - | alcohol | |
| 10 | α-Phellandrene | 10.232 | 869 | 2.38 | 0.34 | 2.69 | 0.33 | monoterpene |
| 11 | 3-Carene | 10.471 | 879 | - | 0.49 | 0.72 | monoterpene | |
| 12 | p-Cymene | 10.623 | 883 | - | 3.81 | 2.16 | monoterpene | |
| 13 | Limonene | 10.696 | 886 | 2.97 | 0.47 | 11.92 | 16.80 | monoterpene |
| 14 | Eucalyptol | 10.784 | 879 | - | 0.47 | 0.59 | 16.80 | monoterpene |
| 15 | Gamma-terpinene | 11.269 | 906 | - | 2.13 | - | 1.65 | monoterpene |
| 16 | Linalool | 11.993 | 930 | - | 0.47 | 0.88 | 2.24 | monoterpene |
| 17 | α-Campholenal | 12.565 | 949 | - | - | 0.46 | - | monoterpene |
| 18 | trans-Pinocarveol | 12.856 | 958 | - | - | 1.27 | - | monoterpene |
| 19 | cis-Verbenol | 12.921 | 961 | - | - | 2.09 | - | monoterpene |
| 20 | Camphor | 12.964 | 962 | - | - | - | 2.18 | monoterpene |
| 21 | Borneol | 12.973 | 963 | - | 1.49 | - | - | monoterpene |
| 22 | p-Menta-1,5-dien-8-ol | 13.202 | 970 | - | - | 0.74 | - | monoterpene |
| 23 | iso-Borneol | 13.346 | 975 | - | 1.82 | - | 0.46 | monoterpene |
| 24 | Levomentol | 13.398 | 976 | - | - | - | 0.19 | monoterpene |
| 25 | Terpinen-4-ol | 13.519 | 980 | - | 0.95 | 2.17 | 0.26 | monoterpene |
| 26 | p-Cymen-8-ol | 13.619 | 984 | 0.39 | - | monoterpene | ||
| 27 | L- α-Terpineol | 13.745 | 988 | - | 1.24 | 1.11 | 2.11 | monoterpene |
| 28 | (-)-Myrtenol | 13.861 | 992 | - | - | 0.51 | - | monoterpene |
| 29 | D-Verbenone | 14.117 | 1000 | - | - | 0.80 | - | monoterpene |
| 30 | cis-p-Mentha-2,8-dien-1-ol | 14.213 | 1003 | - | - | 0.46 | - | monoterpene |
| 31 | Linalyl acetate | 14.728 | 1020 | - | - | 0.54 | - | monoterpene |
| 32 | Citral | 15.028 | 1030 | - | - | - | 1.66 | monoterpene |
| 33 | Cinnamaldehyde | 15.127 | 1034 | - | - | - | 11.44 | monoterpene |
| 34 | 4-Hydroxy-3-methyl-acetophenone | 15.561 | 1048 | - | - | 1.03 | - | ketone |
| 35 | Copaene | 16.913 | 1093 | - | - | 0.78 | - | sesquiterpene |
| 36 | α-Elemene | 17.130 | 1100 | - | - | 1.32 | - | sesquiterpene |
| 37 | α-Caryophyllene | 17.655 | 1119 | - | - | 3.60 | - | sesquiterpene |
| 38 | α-Humulene | 18.184 | 1137 | 0.84 | 1.98 | 0.84 | - | sesquiterpene |
| 39 | 2,4-Nonadienal | 15.413 | 1043 | 3.47 | - | - | - | aldehyde |
| 40 | Piceol | 15.553 | 1048 | 2.36 | - | - | - | phenol |
| 41 | Carvacrol | 15.578 | 1049 | - | 71.07 | - | - | monoterpene |
| 42 | 2,4-Decadienal | 15.795 | 1056 | 4.42 | - | - | - | aldehyde |
| 43 | Eugenol | 16.528 | 1081 | - | 0.38 | - | 35.85 | monoterpene |
| 44 | β-Caryophyllene | 17.664 | 1119 | - | 1.27 | - | 0.14 | sesquiterpene |
| 45 | β-Humulene | 18.188 | 1137 | - | 0.29 | - | - | sesquiterpene |
| 46 | E-2-Tridecen-1-ol | 18.361 | 1143 | 7.10 | - | - | - | alcohol |
| 47 | Bergamotene | 18.636 | 1153 | 1.70 | - | - | - | sesquiterpene |
| 48 | Selina-3,7 (11)-diene | 18.678 | 1154 | - | - | 0.50 | - | sesquiterpene |
| 49 | Aromadendrene | 18.795 | 1158 | - | - | 1.03 | - | sesquiterpene |
| 50 | trans-Cubenol | 19.064 | 1168 | - | - | 1.20 | - | sesquiterpene |
| 51 | β- Farnesene | 19.086 | 1168 | 1.88 | - | - | - | sesquiterpene |
| 52 | Cadina-1(6),4-diene | 19.129 | 1170 | - | 0.89 | - | sesquiterpene | |
| 53 | Caryophyllene oxide | 20.126 | 1205 | - | 0.45 | 2.40 | - | sesquiterpene |
| 54 | (-)-Globulol | 20.243 | 1209 | - | - | 0.79 | - | sesquiterpene |
| 55 | τ-Cadinol | 20.841 | 1231 | - | - | 1.18 | - | sesquiterpene |
| 56 | aR-Turmerone | 21.075 | 1240 | 12.34 | - | - | - | sesquiterpene |
| 57 | (Z)-γ-Atlantone | 21.136 | 1242 | 19.95 | - | - | - | sesquiterpene |
| 58 | β-Turmerone | 21.589 | 1258 | 14.24 | - | - | - | sesquiterpene |
| 59 | α-Ketostearic acid | 22.541 | 1293 | 2.57 | - | - | - | acid |
| 60 | E-2-Tetradecen-1-ol | 23.179 | 1318 | 2.88 | - | - | - | alcohol |
| 61 | Z-1,9-Hexadecadiene | 23.408 | 1327 | 1.78 | - | - | - | alkadiene |
| 62 | E-11-Hexadecenal | 23.898 | 1346 | 0.67 | - | - | - | aldehyde |
| 63 | Farnesol | 24.149 | 1355 | 7.29 | - | - | - | sesquiterpene |
| Total | 99.93 | 99.89 | 99.39 | 99.76 |
| Control | O | O Dried | AM | AM Dried | CU | CU Dried | H | H Dried | T | T Dried | Attribution |
|---|---|---|---|---|---|---|---|---|---|---|---|
| 3306 | 3305 | 3296 | 3305 | 3292 | 3306 | 3296 | 3332 | 3296 | 3306 | 3296 | Amide A: NH stretch coupled with a hydrogen bond |
| - | - | 2937 | - | 2938 | - | 2933 | - | 2937 | - | 2938 | Amide B: CH2 asymmetrical stretch |
| 1638 | 1638 | 1652 | 1638 | 1657 | 1638 | 1651 | 1638 | 1656 | 1638 | 1657 | Amide I: C=O stretch/hydrogen bond coupled with COO– |
| - | - | - | - | - | - | 1556 | - | 1556 | - | - | Amide II: NH bend coupled with an CN stretch |
© 2020 by the authors. Licensee MDPI, Basel, Switzerland. This article is an open access article distributed under the terms and conditions of the Creative Commons Attribution (CC BY) license (http://creativecommons.org/licenses/by/4.0/).
Share and Cite
Dascalu, L.M.; Moldovan, M.; Prodan, D.; Ciotlaus, I.; Popescu, V.; Baldea, I.; Carpa, R.; Sava, S.; Chifor, R.; Badea, M.E. Assessment and Characterization of Some New Photosensitizers for Antimicrobial Photodynamic Therapy (aPDT). Materials 2020, 13, 3012. https://doi.org/10.3390/ma13133012
Dascalu LM, Moldovan M, Prodan D, Ciotlaus I, Popescu V, Baldea I, Carpa R, Sava S, Chifor R, Badea ME. Assessment and Characterization of Some New Photosensitizers for Antimicrobial Photodynamic Therapy (aPDT). Materials. 2020; 13(13):3012. https://doi.org/10.3390/ma13133012
Chicago/Turabian StyleDascalu (Rusu), Laura Monica, Marioara Moldovan, Doina Prodan, Irina Ciotlaus, Violeta Popescu, Ioana Baldea, Rahela Carpa, Sorina Sava, Radu Chifor, and Mindra Eugenia Badea. 2020. "Assessment and Characterization of Some New Photosensitizers for Antimicrobial Photodynamic Therapy (aPDT)" Materials 13, no. 13: 3012. https://doi.org/10.3390/ma13133012







